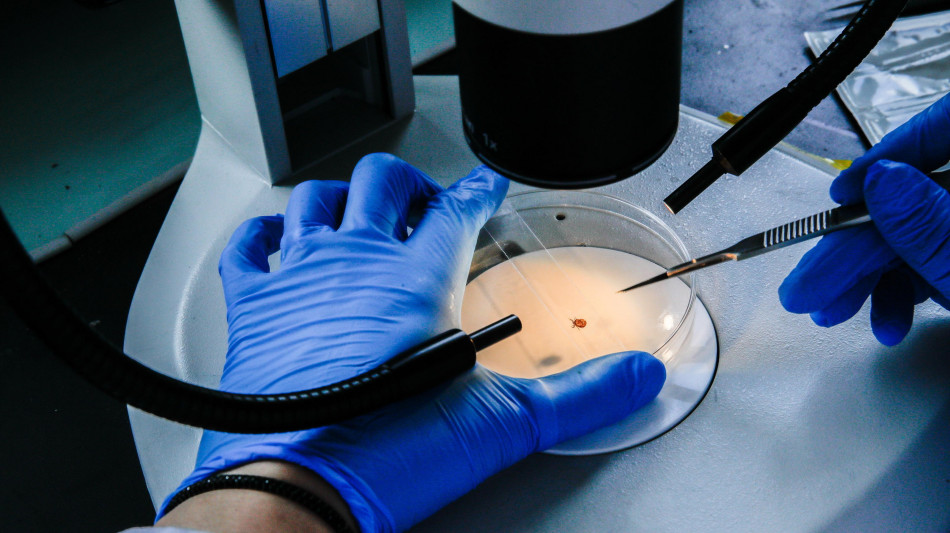
Tumore allo stomaco,oltre 15mila nuove diagnosi l'anno in Italia

Tumore allo stomaco,oltre 15mila nuove diagnosi l'anno in Italia
Oncologi, tra le priorità individuare la corretta stadiazione
Sono oltre 15mila le nuove diagnosi di tumore dello stomaco e della giunzione gastro-esofagea che ogni anno vengono fatte in Italia. Grazie alla ricerca sono disponibili nuovi farmaci, motivo di speranza per malati e caregiver. Tuttavia rimane il problema delle spese da sostenere per i test diagnostici e le cure. Emerge da un expert meeting sulla patologia oncologica, promosso e realizzato da Isheo (Integrated Strategies for Health Enhancing Outcomes), al quale partecipano medici specialisti, istituzioni, associazioni di pazienti e altri professionisti del settore. Tra gli obiettivi vi è l'intenzione di lavorare, attraverso un network multi-specialistico, per aumentare la consapevolezza sugli attuali bisogni insoddisfatti dei pazienti. "Di solito la sintomatologia si manifesta soprattutto negli stadi avanzati della malattia e ciò comporta diagnosi quasi sempre tardive. Dopo anni di stallo iniziamo a riscontrare significativi progressi grazie all'introduzione di innovativi regimi di terapia. Risulta indispensabile l'accesso per i pazienti a un adeguato testing di campioni tumorali affinché si possano effettivamente ottenere anche le nuove cure", afferma il professor Carmine Pinto, direttore della Struttura complessa di oncologia medica dell'Ausl - Irccs di Reggio Emilia. "E' vitale riuscire ad individuare la corretta stadiazione e per ottenerla è importante una forte collaborazione multispecialistica. L'innovazione tecnologica e l'evoluzione delle cure stanno portando nuove opportunità che vanno sfruttate al meglio", sottolinea il professor Giovanni De Manzoni, direttore del Dipartimento di Scienze chirurgiche, odontostomatologiche e materno-infantili dell'Università di Verona. Il carcinoma dello stomaco è il quinto tumore maligno più comune al mondo nel 2020 e rappresenta la quarta causa di morte per cancro. In Italia le persone che vivono con una diagnosi sono più di 82mila. "Affrontare e convivere con una malattia così importante è estremamente difficile, sia per il paziente che per il caregiver. La nostra Associazione fornisce utili informazioni in modo tale da rendere maggiormente consapevoli i pazienti nella scelta del proprio percorso di cura" sottolinea Claudia Santangelo, presidente dell'Associazione pazienti Vivere Senza Stomaco, Si Può Odv.
T.Wolf--BlnAP

 Roma
Roma

 Milano
Milano
 Palermo
Palermo
 Venezia
Venezia